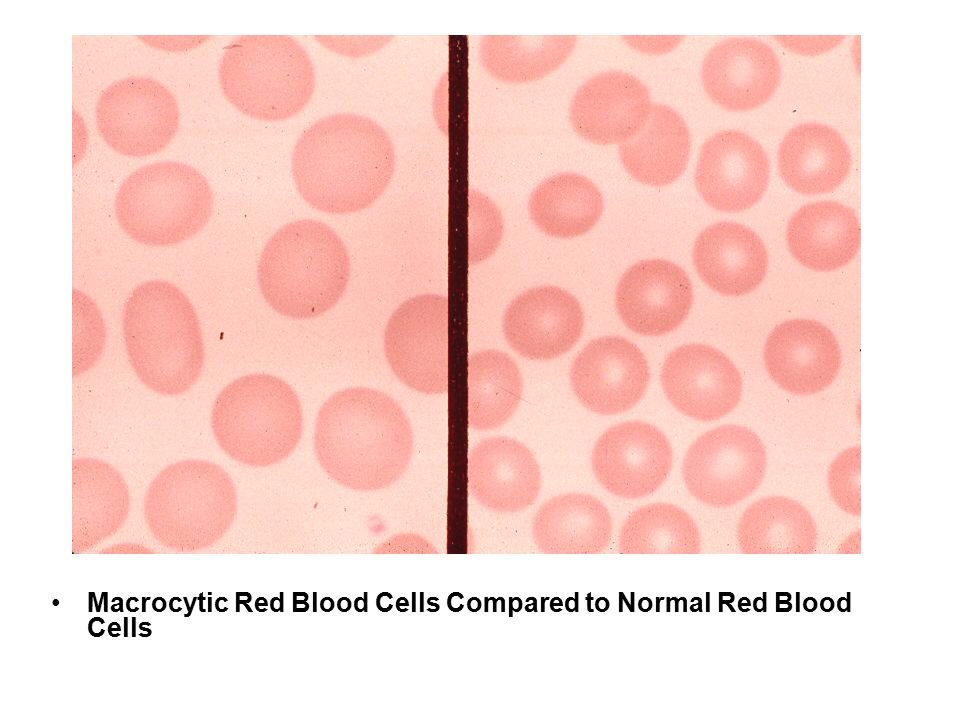

👇شرح طريقة الفحوصات وتشخيصCBC👇
👈كيف تقرأ ال CBC
أولا نعرف ال RBC الطبيعي بالرجل من 4.5_6.5 مليون⭕
والمرأة من 3.8_5.8 مليون🔴
وال WBC من 4 الف إلى 11 الف⚪
وال Platelet من 150 الف إلى 450 الف⚫
أوك 😉👍
👈كيف تقرأ ال CBC
أولا نعرف ال RBC الطبيعي بالرجل من 4.5_6.5 مليون⭕
والمرأة من 3.8_5.8 مليون🔴
وال WBC من 4 الف إلى 11 الف⚪
وال Platelet من 150 الف إلى 450 الف⚫
أوك 😉👍
🙏الاحتمال الثالث حالات فردية
لو لقيت نقص⬇ بال RBC فقط والباقي طبيعي
هنا بتقول أنيميا ولازم تأكد كلامك وتشوف الHb كم👌🏻
Hb less than 13.5 in male= anemia
Hb less than 12 in female= anemia
يعني بالمختصر أحفظ
11= امرأة
12 = رجل
13=طفل
14=رضيع
لو نقص الHb عن أي واحد فهو أنيميا
لو لقيت نقص⬇ بال RBC فقط والباقي طبيعي
هنا بتقول أنيميا ولازم تأكد كلامك وتشوف الHb كم👌🏻
Hb less than 13.5 in male= anemia
Hb less than 12 in female= anemia
يعني بالمختصر أحفظ
11= امرأة
12 = رجل
13=طفل
14=رضيع
لو نقص الHb عن أي واحد فهو أنيميا
وعشان تعرف الانيميا ايش من نوع؟؟؟؟
لازم تشوف ال
MCV normal = 78_98 femto
MCH normal = 27_31 pico
MCHC normal = 32_36 deci
لو لقيتهم كلهم نازلين
MCV,⬇MCH⬇,MCHC⬇
هذا يسمى
Microcytic hypochromic anemia
لازم تشوف ال
MCV normal = 78_98 femto
MCH normal = 27_31 pico
MCHC normal = 32_36 deci
لو لقيتهم كلهم نازلين
MCV,⬇MCH⬇,MCHC⬇
هذا يسمى
Microcytic hypochromic anemia
🙇اما لو ارتفعت ال WBC بينما ال
RBC Platelet =normal
هنا فكر ب infection
وشوف على حسب الزيادة بأي نوع بتعرف نوع العدوى!!!
RBC Platelet =normal
هنا فكر ب infection
وشوف على حسب الزيادة بأي نوع بتعرف نوع العدوى!!!
Never Let Monkey Eat Banana🐵🍌
N=neutrophils
L=lymphocytes
M=monocytes
E=eosinophil
b= basophils
لو زادت neutrophils العدوى بكتيريا
لو lymphocytes العدوى فيروسية
لو monocytes العدوى glandular fever
لو eosinophils العدوى parasites or allergic
لو زادت basophils =
Immune disease
N=neutrophils
L=lymphocytes
M=monocytes
E=eosinophil
b= basophils
لو زادت neutrophils العدوى بكتيريا
لو lymphocytes العدوى فيروسية
لو monocytes العدوى glandular fever
لو eosinophils العدوى parasites or allergic
لو زادت basophils =
Immune disease
وبالتوفيق للجميع👌🏻✨✨
جاري تحميل الاقتراحات...